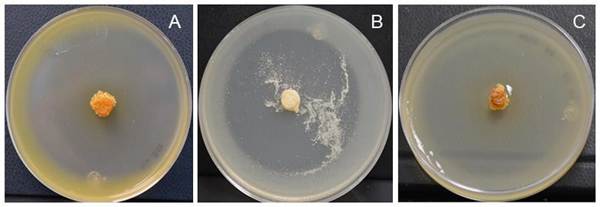

Introducción
El frijol (Phaseolus vulgaris) forma parte de la dieta básica en regiones de África, Latinoamérica y países como India; en 2020 la producción mundial fue de 27 546 millones de toneladas; siendo India el principal productor aportando el 19.8 % de la producción mundial seguido de Myanmar (11.1 %), Brasil (11 %), Estados Unidos (4.9 %), China (4.1 %) y México (4 %) (FAO, 2020). Lo anterior, muestra que el frijol es uno de los principales cultivos a nivel mundial; por lo cual, es de vital interés su manejo agronómico y principalmente el control de las enfermedades que lo afectan. Pseudomonas syringae, es una especie compleja que incluye alrededor de 60 patovares con virulencia específica en una amplia gama de hospedantes (Xin et al., 2018). Pseudomonas syringae pv. phaseolicola (PSPH), es el agente causal de la enfermedad llamada “tizón de halo” y se considera la principal limitante en el cultivo de frijol (O'Leary et al., 2016). Se ha detectado a esta bacteria en diversas regiones de producción del Valle de México y Sinaloa donde su agresividad provoca pérdidas de hasta 55 % de la cosecha (Mamoucha et al., 2023). Generalmente, el control de la bacteria, es con la aplicación de bactericidas químicos; sin embargo, su uso constante ha ocasionado resistencia del patógeno y otros problemas, principalmente los medioambientales y daños a la salud (Miller et al., 2022; Zang et al., 2023). Ante esta problemática, es necesario encontrar alternativas de control que eviten la generación de resistencia en el patógeno, que sean amigables con el ambiente y, sobre todo, encaminadas al desarrollo de una agricultura sostenible.
En la actualidad el uso de microorganismos antagonistas como las actinobacterias y sus metabolitos son utilizadas en el control de enfermedades como una alternativa sustentable en cultivos de importancia económica (Kour et al., 2019; Trinidad-Cruz et al., 2021), han llamado la atención como alternativa sustentable disminuyendo así el uso de pesticidas. Las actinobacterias constituyen el mayor phylum en el dominio bacteria, son Gram-positivas y contienen altos contenidos de guanina y citosina en su genoma, tienen la capacidad de formar esporas (Khushboo et al., 2022), su morfología puede ser desde unicelulares hasta formas filamentosas (Parte et al., 2020). Las actinobacterias, son conocidas por la capacidad de producir una gran cantidad de metabolitos secundarios con distintos efectos, entre los principales, se encuentra la promoción del crecimiento vegetal (Donald et al., 2022; Khushboo et al., 2022); lo cual se potencializa al sintetizar enzimas que solubilizan fosfatos, fijan nitrógeno; y la síntesis de fitohormonas como el ácido indol acético y ácido giberélico, que son importantes reguladores del crecimiento vegetal (Anwar et al., 2016).
Por otro lado, los metabolitos con actividad antimicrobiana que sintetizan las actinobacterias, han mostrado su eficacia en el control de enfermedades de plantas tanto a nivel in vitro como in vivo (Passari et al., 2016; Trinidad-Cruz et al., 2021). Entre los mecanismos y/o estrategias de biocontrol de los actinomicetos se incluyen, el parasitismo (El-Tarabily et al., 2006), producción de sideróforos (Shrivastava y Kumar, 2018), producción de enzimas extracelulares como celulasas, amilasas y quitinasas (Singh y Gaur, 2016), la inducción de resistencia sistémica en plantas (Sharma y Salwan, 2018) y producción de metabolitos secundarios con actividad antimicótica y antibacterial (Westhoff et al., 2021; Khushboo et al., 2022). Los actinomicetos producen cerca de la mitad de todos los antibióticos utilizados en la industria (Bérdy, 2012). Streptomyces, es el género más representativo en el suelo (Qin et al., 2015; Olanrewaju y Babalola, 2019), y mayor productor de metabolitos secundarios (Wohlleben et al., 2016). Así mismo, se ha mostrado la eficacia de sus metabolitos volátiles y no volátiles producidos en diferentes medios (líquido, sólidos y semisólidos), así como sus filtrados (Yang et al., 2019; Trinidad-Cruz et al., 2021). Al respecto Nguyen et al. (2015) y Abbasi et al. (2021), muestran la inhibición del crecimiento de Phytophthora capsici utilizando distintas cepas Streptomyces spp. in vitro. Chen et al. (2016), reportó que el extracto de S. plicatus B4- 7, inhibió el desarrollo in vitro de P. capsici, P. cinnamomi, P. palmivora y P. parasitica en un 55, 65, 43.8 y 35 %, respectivamente. Yan et al. (2019), reportaron que S. corchorusii AUH-1 inhibió el desarrollo de P. capsici y P. parasitica var. nicotianae en un 67.2 y 78.9 %, al aplicar un extracto obtenido por fermentación alcohólica. Zang et al. (2023), reportaron una inhibición de Phytophthora sp. con el uso de extractos de Streptomyces atratus en plantas de pimiento. Wen et al. (2024), de igual manera reportaron una fuerte inhibición de Phytophthora sojae con el uso de extractos de Streptomyces sp. Por su parte Trinidad-Cruz et al. (2021), evaluaron el efecto de los actinomicetos ABV38, ABV39 y ABV45 contra P. capsici en medio agar-papa-dextrosa y reportaron una inhibición de 51, 28 y 50 %, respectivamente; posteriormente, al evaluar el sobrenadante del caldo de cultivo de las cepas ABV38 y ABV45 registraron una disminución del daño en plantas de chile serrano var. Camino Real cuando estas se encontraban infectadas con el patógeno. Arora et al. (2018), mencionaron que la cepa de Streptomyces sp. (C-7), produce ácido nalidíxico un antibiótico contra bacterias Gram negativas e inhibe el crecimiento de E. coli y P. aeruginosa en condiciones in vitro. Al- Dhabi et al. (2019), reportaron que una cepa de Streptomyces sp. (Al-Dhabi-97), tiene efecto antimicrobiano contra diversas bacterias cultivadas en distintos medios de cultivo sólido, principalmente agar nutritivo. Por lo anterior, el objetivo de esta investigación fue evaluar, la capacidad de control de extractos de actinomicetos aislados de suelos agrícolas contra Pseudomonas syringae pv. phaseolicola (PSPH), en plantas de frijol cultivadas en invernadero.
Materiales y Métodos
La presente investigación se llevó a cabo durante el período primavera-verano y el experimento se estableció en un invernadero tipo cenital cubierto con plástico calibre 800, que permite una entrada del 80 % de luz incidente; ubicado en las instalaciones del Instituto de Investigaciones Agropecuarias y Forestales de la Universidad Michoacana de San Nicolás de Hidalgo, México. Las condiciones ambientales al interior del invernadero fueron, temperatura promedio de 32 ± 3 °C y humedad relativa del 46 %.
Material vegetal. Para la realización de este trabajo se utilizaron semillas de frijol variedad azufrado, previamente lavadas con agua corriente y desinfestadas (hipoclorito de sodio al 3 %) durante 10 minutos y posterior enjuague con agua corriente; se sembró una semilla por contenedor de plástico de 2 L de volumen que contenían una mezcla esterilizada (condiciones de esterilización en olla de presión a 120 °C, 103Kpa, por 6 h) de perlita, vermiculita y suelo agrícola, en proporción 2:1:1 v/v. Se realizaron riegos periódicos a capacidad de campo con agua desionizada para mantener el sustrato de crecimiento a capacidad de campo.
Material biológico. Los actinomicetos utilizados fueron proporcionados por el Laboratorio de Fitopatología del CIATEJ (Centro de Investigación y Asistencia en Tecnología y Diseño del Estado de Jalisco, México). Los actinomicetos se identificaron como ED65, ED66 y ED 67 (Figura 1), los cuales se obtuvieron de suelos agrícolas cultivados con Agave cupreata del estado de Michoacán, México y que en estudios previos se mostraron porcentajes de inhibición del crecimiento contra PSPH superiores al 80 % (datos no publicados).
Figura 1 Cepas ED65 (A), ED66 (B) y ED 67 (C), mostrando características morfológicas típicas de actinobacterias.
Los actinomicetos se sembraron en medio papa-dextrosa-agar-levadura (PDA-Y), y se almacenaron a 28 °C por 7 días, posteriormente se sembraron dos discos de agar- micelio de 7 mm de diámetro, en matraces que contenían 25 mL de papa-dextrosa-caldo- levadura (PDB-Y), y se incubaron en oscuridad a 28 °C durante cinco días en agitación a 200 rpm. Después de este tiempo se centrifugaron a 13 000 rpm durante 10 min, el sobrenadante se desechó y la pastilla obtenida se lavó con agua destilada estéril por triplicado y se resuspendió en 30 mL de agua desionizada esterilizada.
Producción del extracto filtrado de actinomicetos. Los actinomicetos se sembraron en medio sólido siguiendo la metodología de Ellaiah et al. (2004), con ligeras modificaciones como se explica a continuación: en matraces Erlenmeyer de 250 mL, se colocaron 10 g de sémola humedecida con 12 mL de PDB a pH 7, posteriormente se añadieron 2 mL del inóculo de actinomicetos (1.2-5.6 mg p/p de materia celular seca), la mezcla se incubó durante 12 días a 28 °C. Después del período de incubación, se recolectó el extracto producido por los actinomicetos añadiendo 25 mL de tampón fosfato (8.06 g de NaCl L -1, 0.22 g de KCl L -1, 1.15 g de Na2HPO4 L -1, 0.2 g de KH2HPO4 L -1) a pH
8.0 como lo reportan Adinarayana et al. (2003) y se mantuvieron en agitación a 200 rpm y 4 °C durante 16 horas. Posteriormente, el contenido de cada matraz se centrifugó a 13 000 rpm durante 20 minutos y se filtró a través de una membrana de 0.22 µm (MILLEX®GP). Finalmente, el filtrado se almacenó a 4 °C hasta su uso.
Pseudomonas syringae pv. phaseolicola (PSPH). La cepa de PSPH-1448A, fue proporcionada por el Laboratorio de Fitopatología del CIATEJ, esta cepa fue aislada en 1985 en Etiopía a partir de plantas con síntomas de P. vulgaris (Teverson, 1991) y desde entonces ha sido utilizada como cepa modelo en diversos estudios por su virulencia y patogenicidad a nivel fisiológico y genético (Joardar et al., 2005; Arnold et al., 2011).
Para comprobar su efectividad, en este trabajo se realizaron pruebas previas de patogenicidad y virulencia en frijol, los cuales manifestaron síntomas de la enfermedad (datos no mostrados). La cepa se reactivó y se sembró en medio caldo King B, en agitación a 200 rpm, a 24 °C durante 36 horas y después se centrifugó por 5 minutos a 10 000 rpm. Posteriormente, se lavó con agua desionizada estéril. La pastilla se resuspendió en agua desionizada estéril y posteriormente se ajustó a una densidad óptica, DO600= 2 (2x107 UFC mL -1). Al finalizar el experimento, el patógeno se reaisló a partir de tejido enfermo de las plantas de frijol infectadas y se conservó a 4 ℃ en cajas con PDA para posteriormente conservarlo en glicerol a -20 ℃.
Aplicación del extracto de actinomicetos contra Pseudomonas syringae pv. phaseolicola (PSPH). A los 56 días después de la siembra del frijol, en cada una de las plantas de los respectivos tratamientos (1 planta por unidad experimental), se asperjaron 2 mL de la suspensión de la cepa 1448A de PSPH (2x107 UFC mL -1). Después de 18 h de la inoculación con la bacteria fitopatógena (PSPH), las plantas se asperjaron con 2 mL del extracto de las cepas de los actinomicetos ED65, ED66 y ED67.
Diseño experimental. La unidad experimental fue una maceta con una planta de frijol, utilizando seis repeticiones por tratamiento. Todas las unidades experimentales se distribuyeron en un diseño experimental completamente al azar. Los tratamientos evaluados fueron los siguientes: T1) ED65 + Ps1448A, T2) ED66 + Ps1448A, T3) ED67
+ Ps1448A y dos controles; uno positivo que corresponde a T4) planta enferma (PE) donde solo se asperjó la bacteria fitopatógena sin extracto de actinomicetos; y un control negativo T5) planta sana (PS), donde se asperjó agua esterilizada, sin la aspersión de ningún extracto de actinomiceto ni la bacteria fitopatógena, para que todas las plantas tuvieran el mismo manejo.
Variables de respuesta. A los 16 días después de la inoculación con PSPH-1448A, se registró la sintomatología y el avance de la enfermedad en las plantas, mediante la presencia de manchas por hoja, número de manchas necróticas en las hojas y el número de hojas defoliadas. El nivel de severidad de la enfermedad se determinó mediante una escala cualitativa de siete niveles (0 - 6), la cual describe desde planta sin síntomas foliares (nivel 0), hasta planta muerta debido a la enfermedad (nivel 6). La escala se basó en la descripción visual de la enfermedad dependiendo de la presencia de los halos cloróticos característicos y la necrosis sobre la superficie de las hojas (Candelas-Delgado, 2017).
Análisis estadístico. A los datos cuantitativos se les aplicaron análisis de varianza y prueba de Tukey al 95 % de confianza. Los datos de la escala de severidad, al ser cualitativos, se sometieron a un análisis Kruskal-Wallis e intervalo de la mediana al 95 %. Todos los análisis se realizaron en el paquete estadístico Statgraphics Centurión XVII.
Resultados y Discusión
La sintomatología ocasionada por Pseudomonas syringae pv. phaseolicola, en plantas de frijol reflejado en el número de hojas con manchas necróticas (Figura 2), y número de manchas por hoja (Figura 3), disminuyó significativamente (P<0.05) por la aspersión del extracto de ED65, ED66 y ED67, con respecto al control positivo con la bacteria (plantas enfermas).

Figura 2 Número de hojas con necrosis a 16 días después de la inoculación con Pseudomonas syringae pv. phaseolicola en plantas de frijol. PE = planta enferma; PS = planta sana. Letras diferentes arriba de las barras indican diferencias estadísticas significativas (Tukey, P<0.05). La línea arriba de las barras (Ɪ) representa el error estándar.
Dieciséis días después de la inoculación con el patógeno, el número de hojas con manchas necróticas disminuyó 62 % en plantas tratadas con los extractos de actinomicetos respecto al tratamiento de planta enferma. Por otro lado, las plantas tratadas con ED66, mostraron una disminución en el número de manchas por hoja (Figura 3) de forma estadísticamente similar a las plantas donde no se inoculó el patógeno (plantas sanas).

Figura 3 Número de manchas por hoja a 16 días después de la inoculación con Pseudomonas syringae pv. phaseolicola en plantas de frijol. PE = planta enferma; PS = planta sana. Letras diferentes arriba de las barras indican diferencia estadística significativa (Tukey, P<0.05). La línea arriba de las barras (Ɪ) representa el error estándar.
La aspersión con ED67 y ED65 registró una cantidad similar de hojas con manchas entre las plantas tratadas y fue en promedio un 56 % menor a la cantidad de manchas observadas en las plantas enfermas (control positivo). De acuerdo con lo anterior, es posible que la disminución de la necrosis se deba al efecto de los metabolitos que podría contener el extracto utilizado (Azman et al., 2017; Zang et al., 2023; Wen et al., 2024); lo anterior, limitaría la propagación, capacidad de infección y establecimiento dentro de la planta evitando su reproducción dentro del apoplasto y la aparición de síntomas (O'Leary et al., 2016). Otro posible mecanismo es la inducción del sistema de defensa sistémica de la planta a través de la síntesis de phaseolina, fitoalexinas y otros compuestos fenólicos, inducidos por la inoculación foliar de los extractos de actinomicetos, los cuales pueden contener propágulos de estos y ejercer un mecanismo indirecto de biocontrol de la enfermedad (Sangiogo et al., 2018; Hata et al., 2021).
La cantidad de manchas por hoja presentó una tendencia similar en todos los tratamientos con respecto a la variable de cantidad de hojas con manchas, registrándose datos numéricos similares. Las hojas de las plantas sin aplicación de los extractos presentaron en promedio siete manchas por hoja a los 56 días después de la inoculación con la bacteria patógena. Mientras que, al aplicar ED65, ED66 y ED67, disminuyó la cantidad de manchas por hoja hasta un promedio de 2.5 manchas por hoja. Esta disminución fue del 75 % respecto a las plantas enfermas y nos indica un efecto de control del patógeno por medio de la aplicación de los extractos de actinomicetos (Figura 2). La aspersión con ED66 registró una reducción de las manchas por hoja, de forma similar estadísticamente a las plantas sanas sin el patógeno. Con base en lo anterior, la actividad antimicrobiana de las cepas evaluadas resultó ser eficaz para el control de PSPH, posiblemente debido a la presencia de compuestos bactericidas en los extractos evaluados, resultados similares han sido reportados en cepas de diferentes especies de Streptomyces como S. lydicus (Atta et al., 2015), S. bingchenggensis (Jin et al., 2020) y
S. peucetius (Nguyen et al., 2021).
En el número de hojas defoliadas, el análisis mostró diferencias estadísticas significativas entre los tratamientos (P < 0,01). Donde, aquellas plantas que se trataron con los extractos de ED65 y ED67, se incrementó el número de hojas defoliadas, evidenciado un posible efecto herbicida sobre las plantas (Figura 4).
Por otro lado, el tratamiento con la aplicación de ED66, registró una defoliación similar a las plantas inoculadas con PSPH. Lo anterior podría deberse a una posible toxicidad que provocó la caída prematura de las hojas y causar quemaduras del tejido (Kim et al., 2020). Se ha reportado que algunas especies de Streptomyces como S. scopuliridis tienen propiedades herbicidas (Lee et al., 2013). En este estudio, los resultados sugieren que los extractos podrían tener un efecto negativo en la planta al disminuir el área foliar necesaria para los procesos fotosintéticos (Bo et al., 2019), por lo tanto, se requieren evaluaciones posteriores para analizar el nivel de fitotoxicidad de los extractos filtrados. Una alternativa para el aprovechamiento de los metabolitos antimicrobianos presentes en los extractos de estas cepas como posible herramienta en el control de PSPH, es determinar la dosis mínima inhibitoria del patógeno, la cual podría no causar fitotoxicidad (Julian et al., 2020). Otra estrategia es la caracterización y el aislamiento de los bioactivos que contienen los extractos e identificar al compuesto con mayor eficacia antimicrobiana, sin causar fitotoxicidad en la planta (Tian et al., 2017).

Figura 4 Número de hojas defoliadas en plantas de frijol a 16 días después de la inoculación con Pseudomonas syringae pv. phaseolicola. PE = planta enferma; PS = planta sana. Letras diferentes arriba de las barras indican diferencias estadísticas significativas (Tukey, P<0.05). La línea sobre las barras (Ɪ) representa el error estándar.
Por otro lado, para el nivel de severidad ocasionado por PSPH, el análisis Kruskal- Wallis registró diferencias estadísticas entre los tratamientos (estadístico = 22.0906, P = 0.0002) (Figura 5).

Figura 5 Nivel de severidad del tizón del halo en Phaseolus vulgaris a 16 días después de la inoculación de Pseudomonas syringae pv. phaseolicola. PE = Planta enferma; PS = Planta sana.
Las plantas inoculadas solo con el fitopatógeno (planta enferma), presentaron los mayores valores de severidad (nivel 4 y 5 de la escala). Por otro lado, los tratamientos con ED65, ED66 y ED67, presentaron un nivel de severidad menor que los tratamientos correspondientes a plantas inoculadas solo con el patógeno. Las plantas tratadas con el extracto ED66, mostraron pocos síntomas de la enfermedad reflejado en la presencia de pocas manchas cloróticas y necróticas en las hojas. El extracto ED67, registró un nivel de severidad de 1 al presentar una menor clorosis y necrosis, el extracto ED65 registró una severidad en nivel 2. En las plantas donde se inoculó la bacteria, los síntomas se manifestaron en las hojas basales a pesar de la aspersión completa con los extractos (Figura 6). Lo anterior podría deberse a que las hojas basales translocan nutrientes hacia las hojas jóvenes incrementando su susceptibilidad (Dordas, 2008). Por otro lado, se requiere del establecimiento de condiciones ambientales adecuadas para el desarrollo de la enfermedad, de tal manera que el patógeno pueda desarrollarse y causar los síntomas de forma similar a como lo hace en campo donde se presenta bajo condiciones cercanas al 100 % de humedad relativa y una temperatura entre 16 y 20 ℃ (Hirano y Upper, 2000; Arnold et al., 2011; Xin et al., 2016; Sun et al., 2017), algunas de estas condiciones, especialmente la temperatura, no coincidieron con las condiciones experimentales del presente trabajo.
Conclusiones
Los extractos de actinomicetos evaluados en el presente trabajo mostraron actividad antimicrobiana sobre PSPH, en especial el extracto del aislado ED66, redujo en más del 90 %, los síntomas del tizón del halo del frijol reflejado en un menor daño foliar. A pesar de que los extractos registraron fitotoxicidad en las hojas, es posible realizar evaluaciones posteriores relacionadas con el aislamiento y caracterización de los compuestos bioactivos y su posible empleo en el desarrollo de productos de control contra PSPH.















